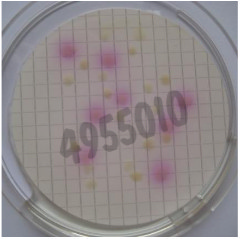
Nutrient pad 50mm ecd mug-nps with indolkit e. coli (direct detection) 50 pcs

Autres produits pour culture cellulaire
1495 produits - Trié par pertinence
Nutrient pad 50mm ecd mug-nps with indolkit e. coli (direct detection) 50 pcs
Réf. UGAP : 3661007 Réf. constructeur : 1080
Di-sodium hydrogénophosphate anhydre selon pharmacopée européenne us et uk, pur, qualité pharma 1 kg
Réf. UGAP : 3666464 Réf. constructeur : 141679.1211
Yatalase (pour digestion de la paroi cellulaire des champignons filamenteux) 2 g
Réf. UGAP : 3631056 Réf. constructeur : T017
DPBS, with MgCl2 and CaCl2, liquid, sterile-filtered, suitable for cell culture
Réf. UGAP : 4101134 Réf. constructeur : D8662-500ML
Solution Saline de EARLE HAUTE TEMPERATURE Liquide 10X 6x100 mL
Réf. UGAP : 3612832 Réf. constructeur : CS3SSE14-6U
Kit de proliferation cellulaire wst-8 1000 tests 1 Kit
Réf. UGAP : 3664810 Réf. constructeur : WS1000